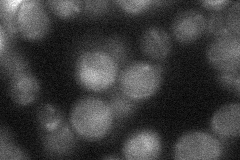
YGR109C
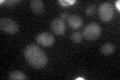
YGR109C

View description
B-type cyclin involved in DNA replication during S phase; activates Cdc28p to promote initiation of DNA synthesis; functions in formation of mitotic spindles along with Clb3p and Clb4p; most abundant during late G1
Localization:
Intensity:
Fold change:
Significance:
-
C’ GFP library in SD

below threshold16.06 -
N' NOP1pr-GFP in SD

nucleus20.7724 -
N' TEF2pr-mCherry in SD

missing0 -
N' NATIVEpr-GFP in SD
below threshold19.7167 -
N' TEF2pr-VC and Cyto-VN in SD

#N/A0 -
C’ GFP library in SD+DTT

cytosol15.480.96No -
C’ GFP library in SD+H2O2

cytosol16.361.01No -
C’ GFP library in Starvation Media
cytosol27.71.72No -
C’ GFP library on the background of Pup2-DaMP

below threshold -
C’ GFP library on the background of CCT mutant

below threshold17.09571.06379No
